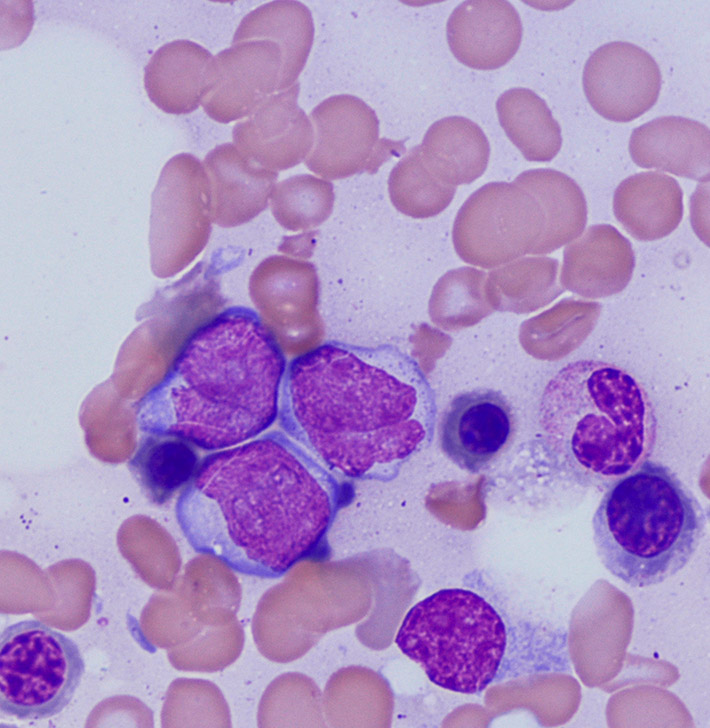

CURSO PRÁCTICO DE CITOLOGÍA EN DERRAMES Y LÍQUIDOS CORPORALES
3 Y 4 DE JUNIO 2023
WALTER BERTAZZOLO
CONOCE LOS DETALLES >

3 Y 4 DE JUNIO 2023
WALTER BERTAZZOLO

27 Y 28 DE MAYO 2023
ELENA MARTINEZ DE MERLO
21 DE SEPTIEMBRE 2023
CRISTINA FERNÁNDEZ ALGARRA

22 DE SEPTIEMBRE 2023
CRISTINA FERNÁNDEZ ALGARRA

26 Y 27 DE OCTUBRE 2023
FRANCESCO ALBANESE


26 Y 27 DE OCTUBRE 2023
ALBA SANZ

10 DE NOVIEMBRE 2023
CARLES JUAN SALLÉS

16 PONENTES
ELENA MARTÍNEZ DE MERLO, WALTER BERTAZZOLO, ALBA SANZ, FRANCESCO ALBANESE, ESTER TORRES, LAIA PALAU, CRISTINA FERNÁNDEZ ALGARRA, FRANCESCO CIAN, MARTINA PIVIANI...